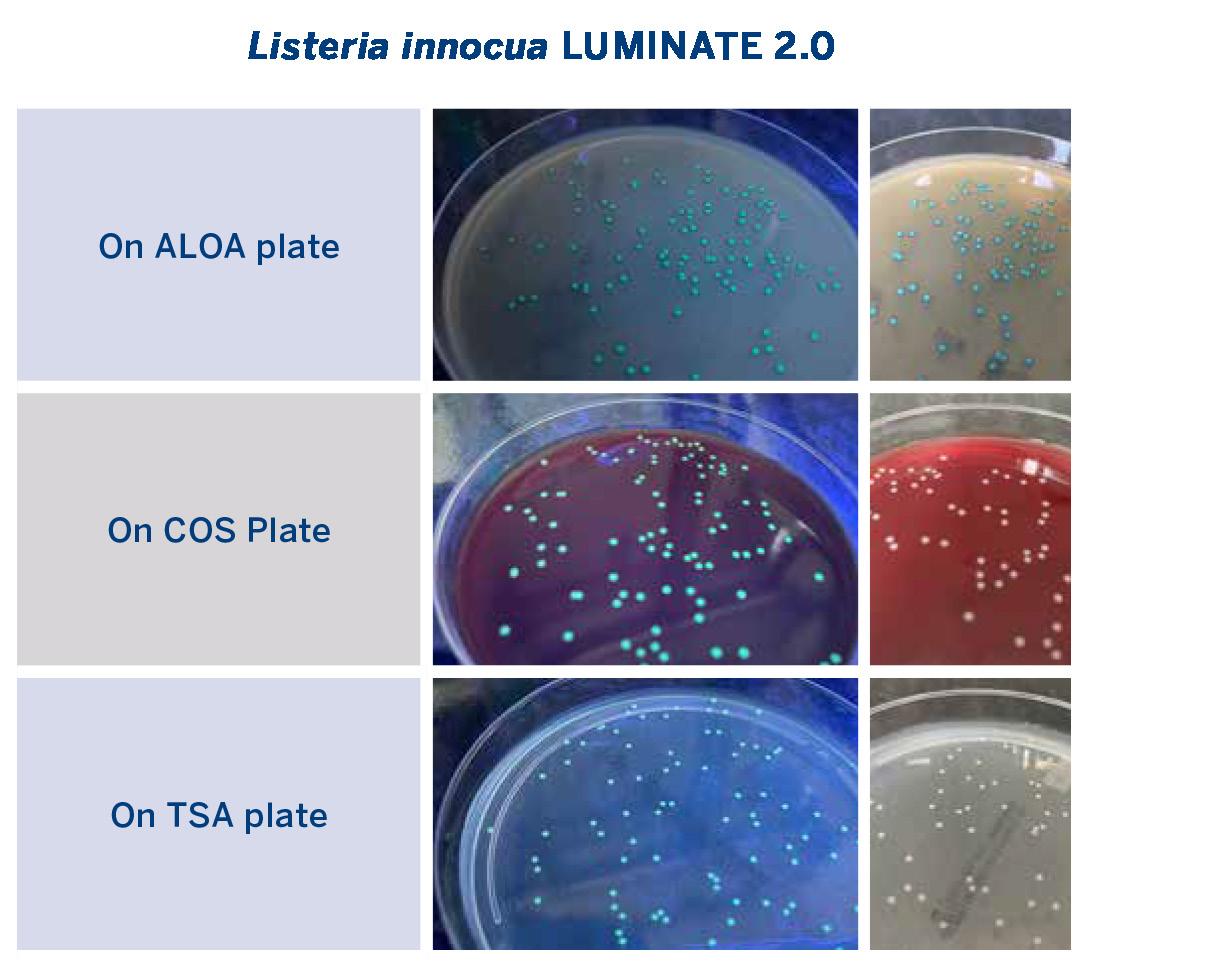
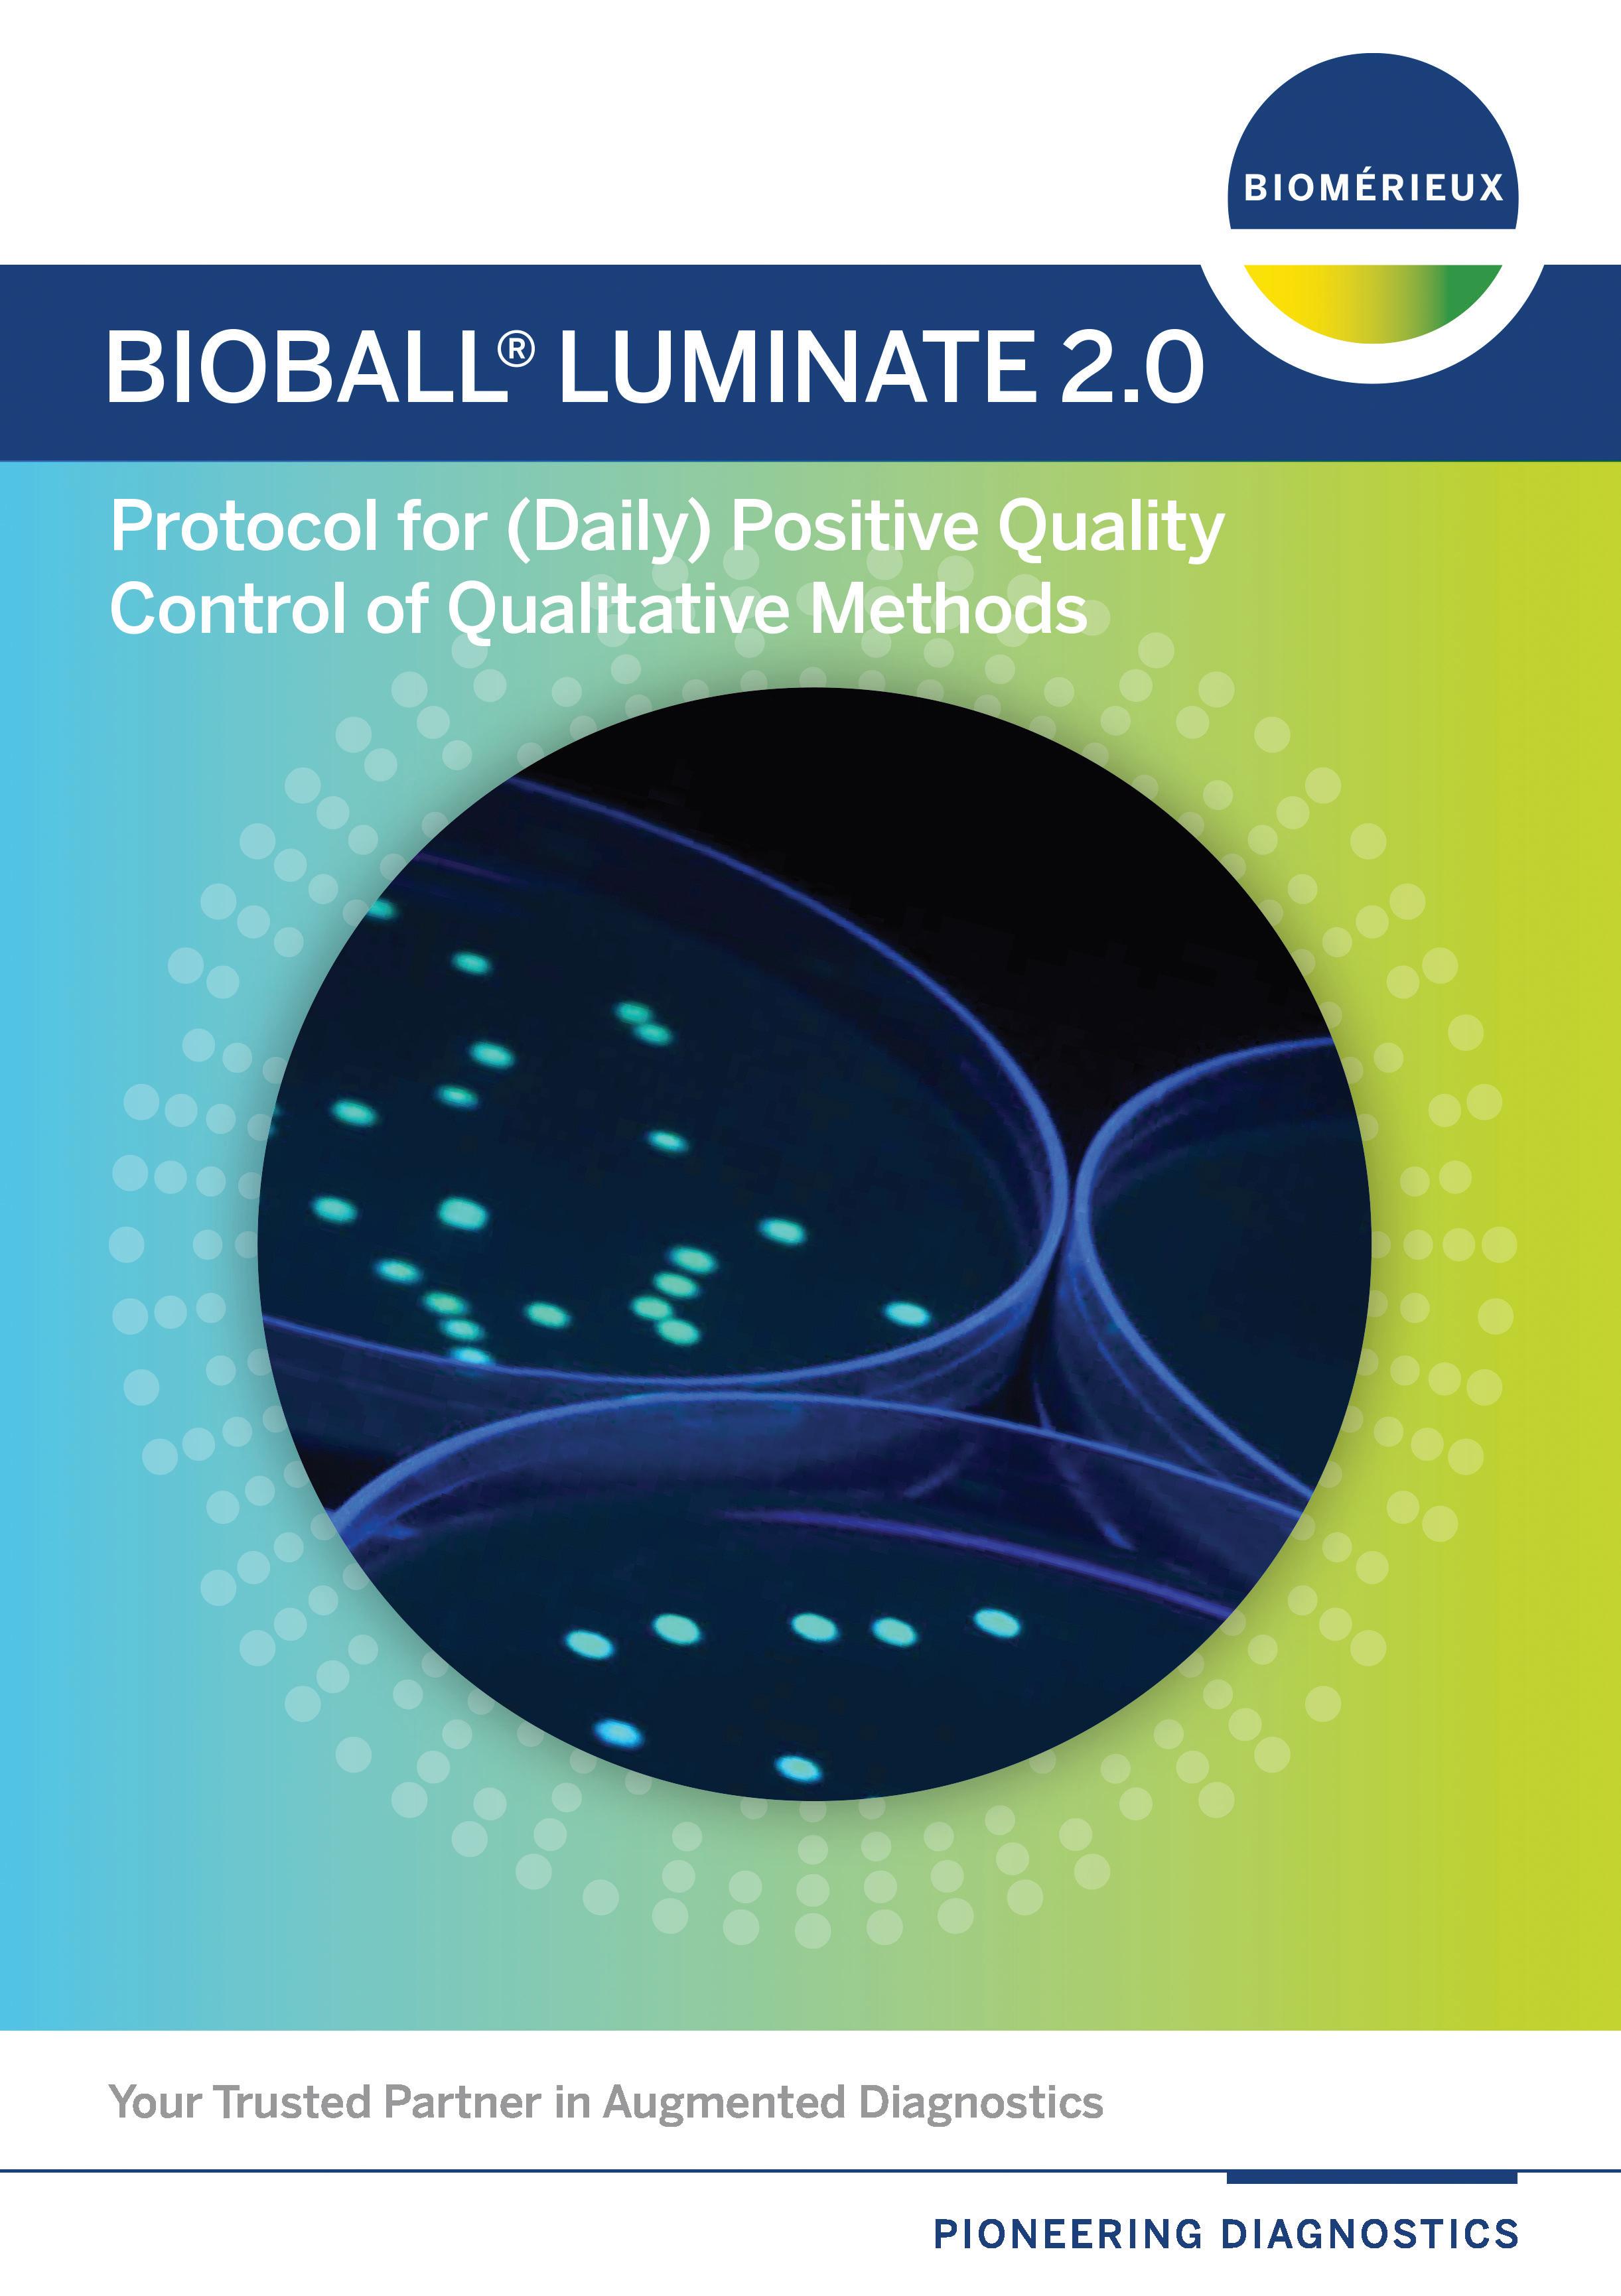

*protective agent: 10 % skim milk plus 1 % monosodium glutamate




Protective media
Application
Most bacteria
Yeasts
Fungi
Liquid drying
Composition
Sodium L(+)-glutamate monohydrate 3 g.
Ribitol 1.5 g., L-cysteine hydrochloride monohydrate 0.05 g.
0.1M potassium phosphate buffer (pH 0.7) 100 ml.
A: Polyvinylpyrrolidone (K-90) 6 g., Lactose 5 g., Distilled water 75 ml.
B: Sodium L(+)-glutamate monohydrate 3 g.
1M potassium phosphate buffer (pH 0.7) 10 ml., Distilled water 15 ml.
Sterilized separately by autoclaving, then mix A&B.
Sodium L(+)-glutamate monohydrate 3 g.
0.1M potassium phosphate buffer (pH 0.7) 100 ml
1% Activated charcoal added in protective media for lactic acid bacterial 5% Trehalose added in protective media for yeasts


Freezing (sporulating fungi, yeasts and bacteria)

Freezing (non-sporulating filamentous fungi)

Reviving frozed cultures







Preparation of back up, stock and working cultures